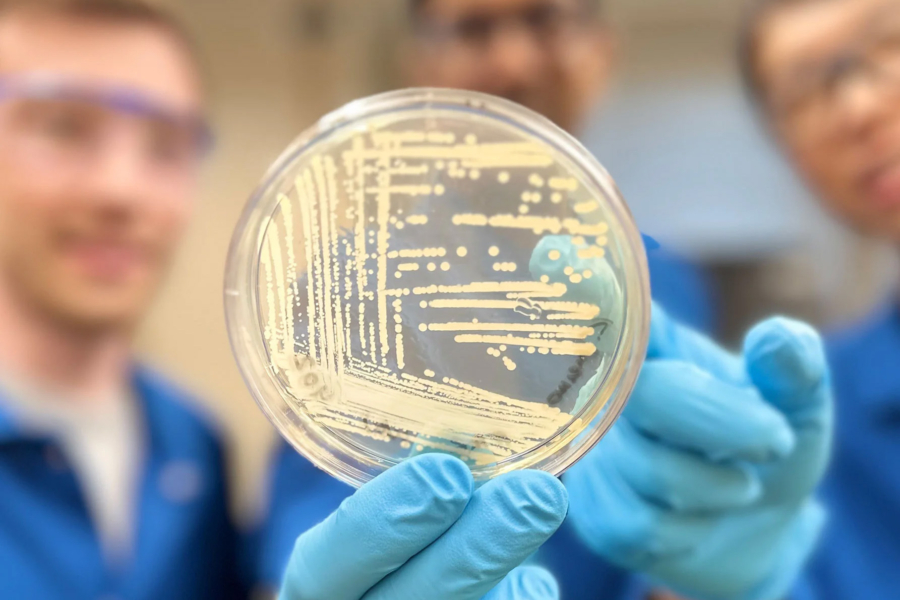
Harvard a dezvoltat un nou antibiotic sintetic

- Un nou antibiotic sintetic, dezvoltat de Harvard, ar putea salva milioane de vieți în fața infecțiilor mortale.
- Cresomicina este un compus inovator care a furnizat rezultate promițătoare împotriva bacteriilor rezistente la medicamentele pe care le avem în prezent.
- Potrivit Centrului american pentru Prevenirea şi Controlul Bolilor (CDC), în fiecare an apar peste 2,8 milioane de infecții rezistente la antimicrobiene.
Un nou antibiotic sintetic, dezvoltat de Harvard, ar putea salva milioane de vieți în fața infecțiilor mortale.
Cresomicina este un compus inovator care a furnizat rezultate promițătoare împotriva bacteriilor rezistente la medicamentele pe care le avem în prezent. Această rezistență antimicrobiană apare atunci când bacteriile evoluează iar acest fenomen a făcut ca multe medicamente sau antibiotice să fie depășite și asta este o amenințare semnificativă la adresa sănătății publice mondiale. Această moleculă sintetică, cresomicina, s-a…